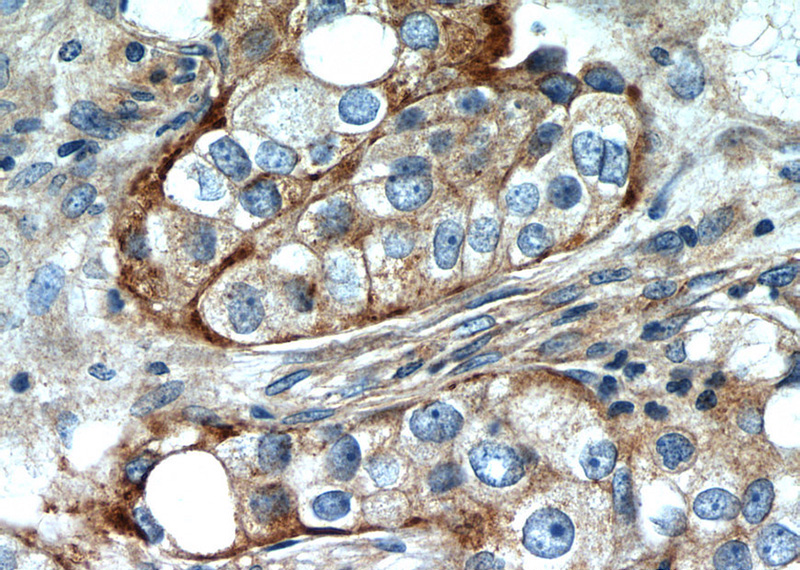
Immunohistochemistry of paraffin-embedded human breast cancer slide using Catalog No:111623(IFITM2 Antibody) at dilution of 1:50

-
Product Name
IFITM2 antibody
- Documents
-
Description
IFITM2 Rabbit Polyclonal antibody. Positive WB detected in MCF-7 cells, human lung tissue. Positive IP detected in HepG2 cells. Positive IHC detected in human breast cancer tissue, human ovary tumor tissue. Positive IF detected in HepG2 cells. Observed molecular weight by Western-blot: 15kd
-
Tested applications
ELISA, IP, IHC, IF, WB
-
Species reactivity
Human; other species not tested.
-
Alternative names
1 8D antibody; IFITM2 antibody
-
Isotype
Rabbit IgG
-
Preparation
This antibody was obtained by immunization of IFITM2 recombinant protein (Accession Number: NM_006435). Purification method: Antigen affinity purified.
-
Clonality
Polyclonal
-
Formulation
PBS with 0.1% sodium azide and 50% glycerol pH 7.3.
-
Storage instructions
Store at -20℃. DO NOT ALIQUOT
-
Applications
Recommended Dilution:
WB: 1:1000-1:10000
IP: 1:200-1:1000
IHC: 1:20-1:200
IF: 1:20-1:200
-
Validations
Immunohistochemistry of paraffin-embedded human breast cancer slide using Catalog No:111623(IFITM2 Antibody) at dilution of 1:50

MCF-7 cells were subjected to SDS PAGE followed by western blot with Catalog No:111623(IFITM2 Antibody) at dilution of 1:2000

IP Result of anti-IFITM2 (IP:Catalog No:111623, 3ug; Detection:Catalog No:111623 1:300) with HepG2 cells lysate 1720ug.

Immunofluorescent analysis of HepG2 cells using Catalog No:111623(IFITM2 Antibody) at dilution of 1:50 and Rhodamine-Goat anti-Rabbit IgG
-
Background
IFITM2, also named as 1-8D, belongs to the CD225 family. It is an IFN-induced antiviral protein that mediates cellular innate immunity to at least three major human pathogens, namely influenza A H1N1 virus, West Nile virus (WNV), and dengue virus , by inhibiting the early steps of replication. IFITM2 induces cell cycle arrest and mediates apoptosis by caspase activation and in p53-independent manner. It is overexpressed in colon carcinoma. IFITM2 is a novel pro-apoptotic gene that will provide new insights into the regulated cellular pathways to death. IFITM proteins are recently identified as viral restriction factors that inhibit infection mediated by the influenza A virus (IAV) hemagglutinin (HA) protein. Also they serve as important components of the innate immune system to restrict HIV-1 infection. Catalog#12769-1-AP is a rabbit polyclonal antibody produced with full-length of human IFITM2.
-
References
- Jiang D, Weidner JM, Qing M. Identification of five interferon-induced cellular proteins that inhibit west nile virus and dengue virus infections. Journal of virology. 84(16):8332-41. 2010.
- Tartour K, Appourchaux R, Gaillard J. IFITM proteins are incorporated onto HIV-1 virion particles and negatively imprint their infectivity. Retrovirology. 11:103. 2014.
- Qian J, Le Duff Y, Wang Y. Primate lentiviruses are differentially inhibited by interferon-induced transmembrane proteins. Virology. 474:10-8. 2015.
- Compton AA, Bruel T, Porrot F. IFITM proteins incorporated into HIV-1 virions impair viral fusion and spread. Cell host & microbe. 16(6):736-47. 2014.
- Zhang W, Zhang L, Zan Y, Du N, Yang Y, Tien P. Human respiratory syncytial virus infection is inhibited by IFN-induced transmembrane proteins. The Journal of general virology. 96(Pt 1):170-82. 2015.
- Rosati A, Basile A, D'Auria R. BAG3 promotes pancreatic ductal adenocarcinoma growth by activating stromal macrophages. Nature communications. 6:8695. 2015.
- Wrensch F, Winkler M, Pöhlmann S. IFITM proteins inhibit entry driven by the MERS-coronavirus spike protein: evidence for cholesterol-independent mechanisms. Viruses. 6(9):3683-98. 2014.
- Wrensch F, Karsten CB, Gnirß K. Interferon-Induced Transmembrane Protein-Mediated Inhibition of Host Cell Entry of Ebolaviruses. The Journal of infectious diseases. 212 Suppl 2:S210-8. 2015.
Related Products / Services
Please note: All products are "FOR RESEARCH USE ONLY AND ARE NOT INTENDED FOR DIAGNOSTIC OR THERAPEUTIC USE"
